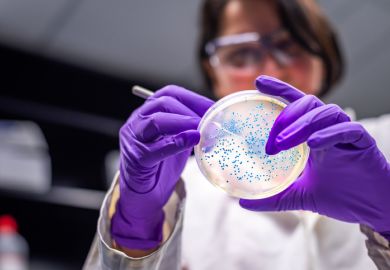

America’s public universities were born in crisis, conceived in 1862 amid the savagery of the Civil War. A year away from the battle of Gettysburg, President Lincoln already was looking ahead to the time he would bind up the wounds of a divided nation. Working with Vermont Senator Justin Morrill, his plans would include the founding of public universities in each state of the union. The healing process was going to include the offering of a college education to the sons and daughters of working-class parents at a cost they could bear.
Fast-forward to the Second World War, and America’s public universities are providing much of the cutting-edge research that contributes to the Allied victory in Europe and the defeat of Japan. The impact of these public institutions of higher learning is so substantial that post-war strategic planning solidified the government’s partnership with universities, eventually giving rise to the National Science Foundation and the National Institutes of Health.
Another leap in time to the present, and the Covid-19 pandemic has brought about another great calamity for America and the world. It is a public health crisis, of course, yet it also is an economic emergency. In the US, stay-at-home orders have ground the economy to a near standstill, creating unemployment figures not seen since the Great Depression of the 1930s.
Unfortunately, many of the nation’s public universities already were on shaky financial ground before the pandemic. Some of these fiscal issues were the result of decreased funding from state legislatures. Shifting demographic trends in terms of the declining numbers of traditional-aged college students also contributed to the economic challenges of these institutions of higher learning.
No doubt, the economic fallout of the Covid-19 pandemic is going to hasten the demise of these already faltering institutions, and it will sorely test others.
For those institutions that do survive, however, they will be strengthened in the long run. The mission of these colleges and universities will become sharpened as they are forced to do more with less. A large component of this fortifying process will involve the rediscovery of the public university’s purpose in terms of meeting the core needs of the communities for which they were designed to serve.
One of those fundamental necessities, dating back to the founding of America’s public universities in 1862, was the offering of a college degree that was both accessible and affordable. Regrettably, in the past several decades a substantial number of public universities have become both less available and more expensive than ever before. The reasons are many and varied, but there are at least two contributing causes that may be fundamentally altered in the aftermath of the Covid-19 pandemic, and they both surround the topic of teaching.
The first issue concerns who we teach. Until recently, most public universities have witnessed a great influx of international students. In addition to creating greater diversity on campus, students from other countries have paid substantially higher tuition charges and fees, thus augmenting university budgets at a time when other sources of revenue were dropping.
What was termed the “golden age” of recruiting international students was already on the decline when the pandemic hit, however, in no small part because of political winds that had shifted as the result of the 2016 US presidential election.
The Covid-19 pandemic will further reduce the presence of these students on US campuses by an even greater factor as travel is restricted and students make decisions to stay closer to home. No doubt this will create additional budget challenges for fiscal officers.
For those who believe in the original mission of our nation’s public universities, however, this not all unwelcome news. Lower numbers of international students will translate into many more positions that will be open for students who are residents of the states providing the taxpayer dollars that support these universities.
Plain and simple, this is an opportunity to create greater access. Opportunely, this renewed focus on residential students may be one opening for university leaders to convince often skeptical lawmakers that there is a need to keep these institutions solvent.
The second issue surrounds the issue of what we teach. Comprehensive public universities historically have offered classes and majors on just about any topic. Those high-minded days largely are over. Institutions of higher learning must shift their focus to the changing demands of society. The pandemic has illuminated our need for healthcare professionals to care for the sick, epidemiologists to track cases, statisticians to create models, and so on.
Those universities that are at the forefront of providing what the public wants and needs to deal with Covid-19 right now will earn a place at the front of the funding queue when this pandemic ends.
Stephen Gavazzi is a professor of human development and family science in the College of Education and Human Ecology at Ohio State University. He is the co-author (along with West Virginia University president E. Gordon Gee) of the 2018 book Land-Grant Universities for the Future: Higher Education for the Public Good.
Register to continue
Why register?
- Registration is free and only takes a moment
- Once registered, you can read 3 articles a month
- Sign up for our newsletter
Subscribe
Or subscribe for unlimited access to:
- Unlimited access to news, views, insights & reviews
- Digital editions
- Digital access to THE’s university and college rankings analysis
Already registered or a current subscriber?